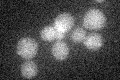
YDR188W
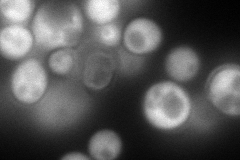
YDR188W
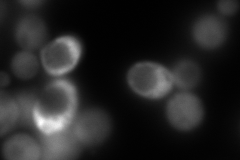
YDR188W
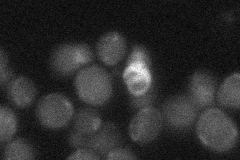
YDR188W
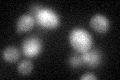
YDR188W

View description
Subunit of the cytosolic chaperonin Cct ring complex, related to Tcp1p, essential protein that is required for the assembly of actin and tubulins in vivo; contains an ATP-binding motif
Localization:
Intensity:
Fold change:
Significance:
-
C’ GFP library in SD
below threshold15.41 -
N' NOP1pr-GFP in SD
cytosol165.142 -
N' TEF2pr-mCherry in SD
cytosol17.5108 -
N' NATIVEpr-GFP in SD
below threshold21.5289 -
N' TEF2pr-VC and Cyto-VN in SD

#N/A0 -
C’ GFP library in SD+DTT
cytosol17.131.11No -
C’ GFP library in SD+H2O2

cytosol15.791.02No -
C’ GFP library in Starvation Media

cytosol18.241.18No -
C’ GFP library on the background of Pup2-DaMP

below threshold -
C’ GFP library on the background of CCT mutant

below threshold16.84681.09238No
